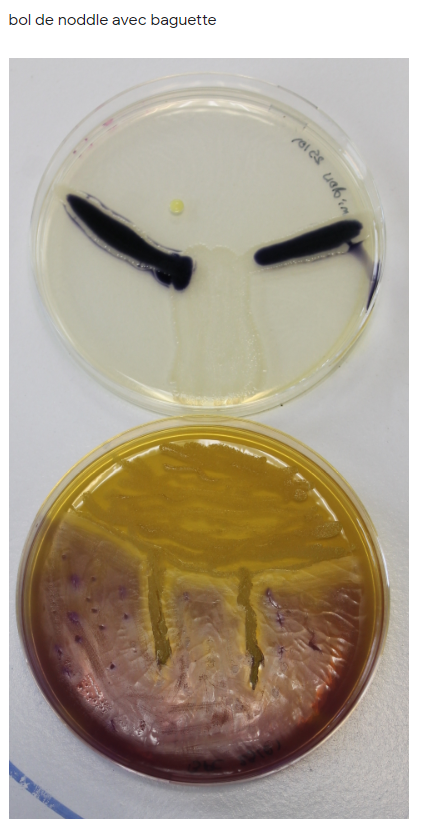
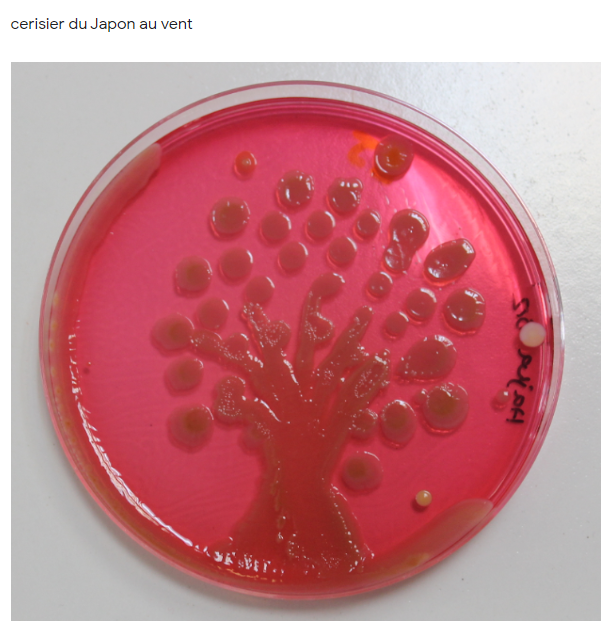
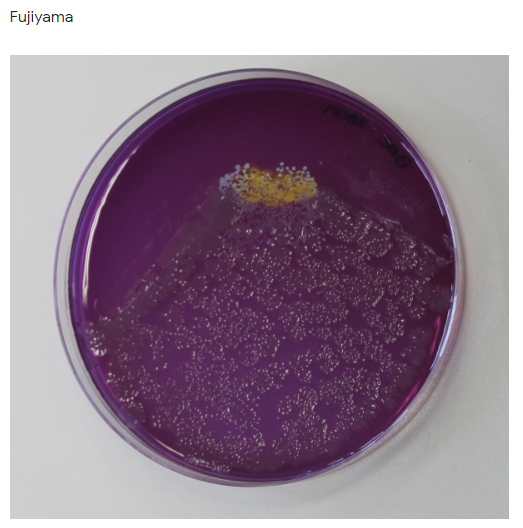
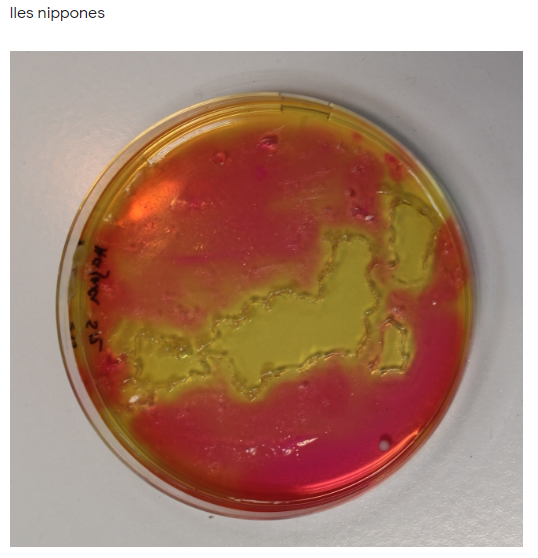
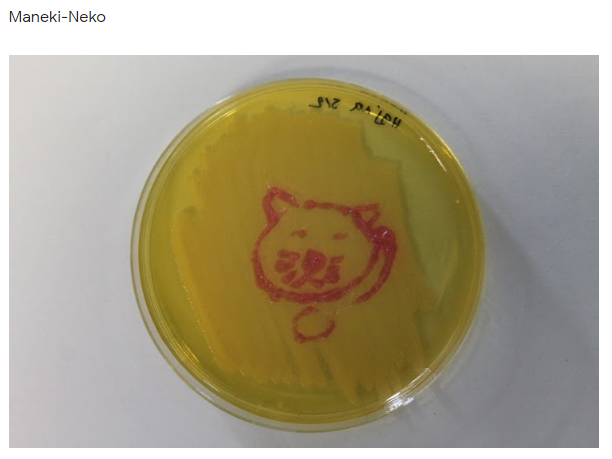
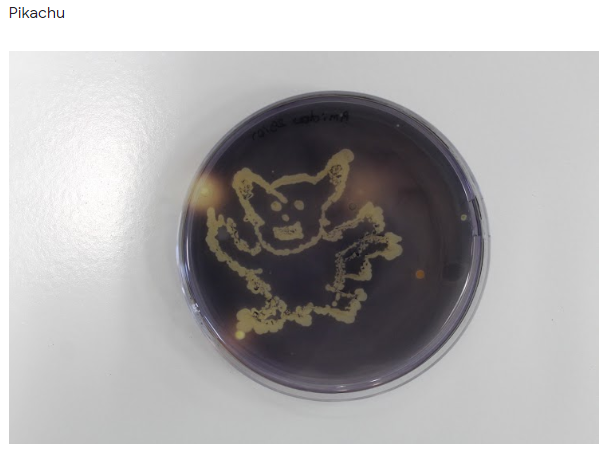
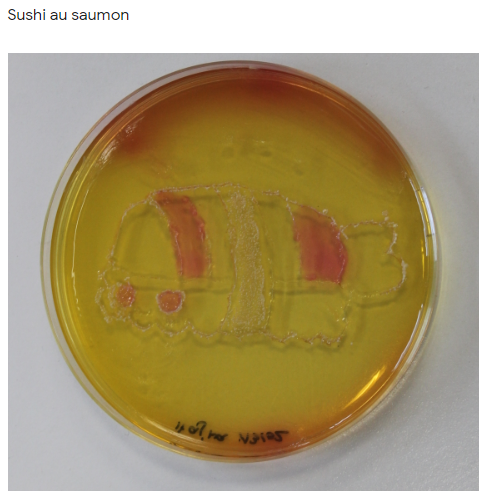
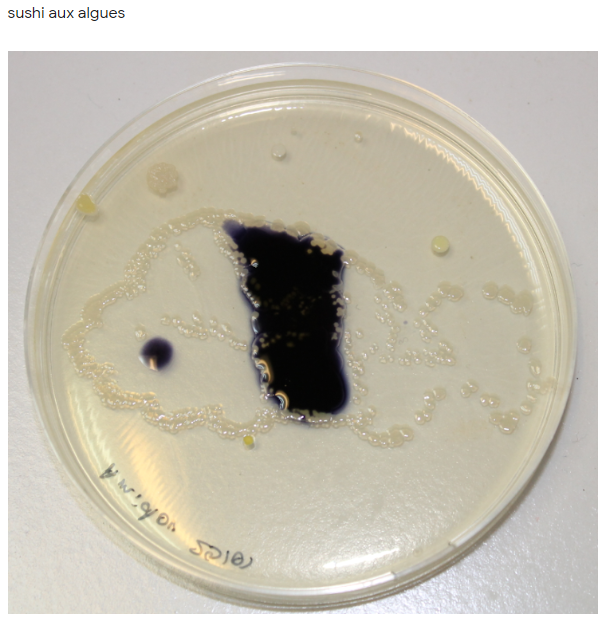
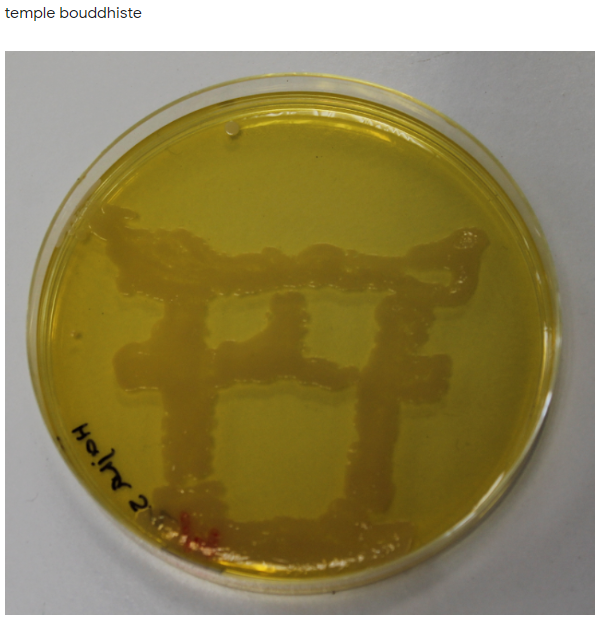
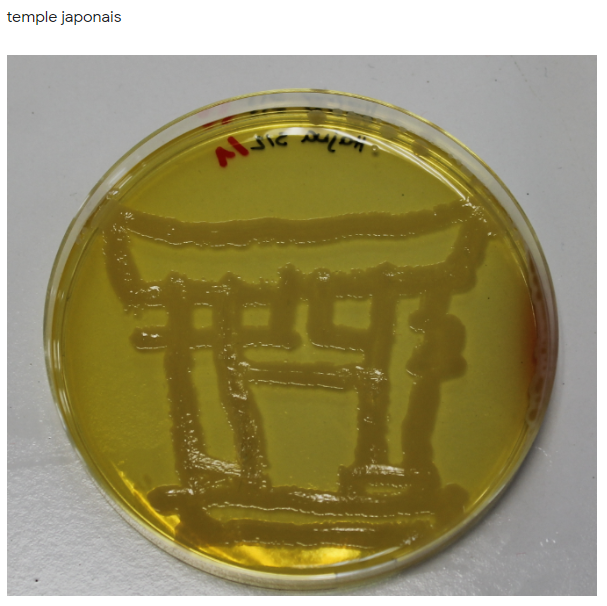
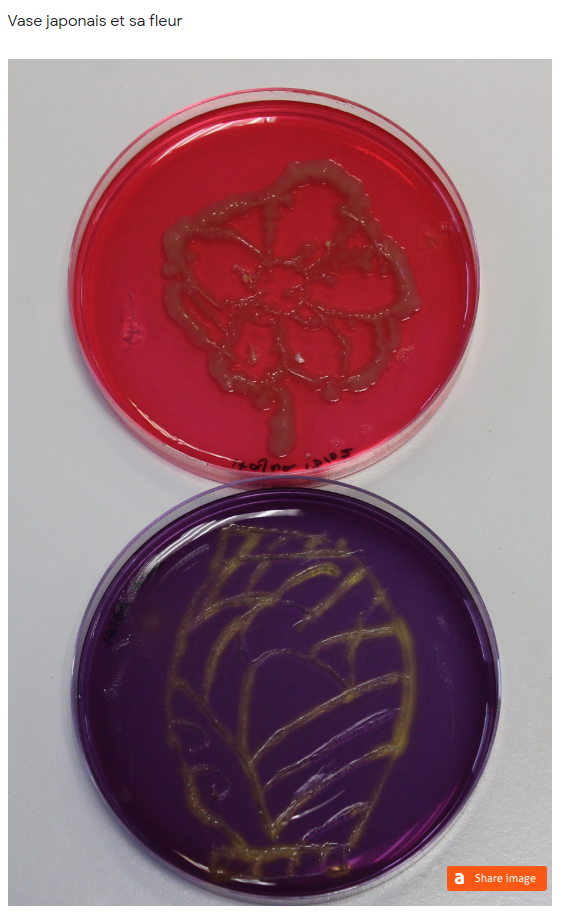

Parmi les 14 productions proposées, votez pour votre préférée afin qu’elle représente le lycée Saint-Paul au concours national d’Agar’Art (développement des bactéries sur milieu nutritif) avant le 21 février 2020 :
https://forms.gle/eJCCavWrGw2bKka66